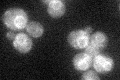
YJR013W
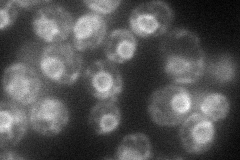
YJR013W
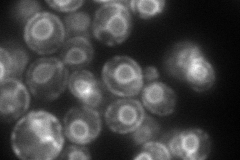
YJR013W
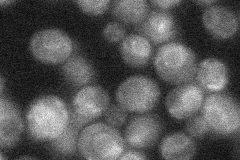
YJR013W
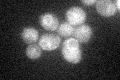
YJR013W

View description
Glycosylphosphatidylinositol-alpha 1,4 mannosyltransferase I, involved in GPI anchor biosynthesis, requires Pbn1p for function; homolog of mammalian PIG-M
Localization:
Intensity:
Fold change:
Significance:
-
C’ GFP library in SD
ER29.57 -
N' NOP1pr-GFP in SD
ER70.9362 -
N' TEF2pr-mCherry in SD
ER108.842 -
N' NATIVEpr-GFP in SD
ER27.9731 -
N' TEF2pr-VC and Cyto-VN in SD

ER,punctate32.66 -
C’ GFP library in SD+DTT

ERN/AN/ANo -
C’ GFP library in SD+H2O2
ERN/AN/ANo -
C’ GFP library in Starvation Media

technical problem0N/AYes -
C’ GFP library on the background of Pup2-DaMP

ER -
C’ GFP library on the background of CCT mutant

ERN/AN/ANo
